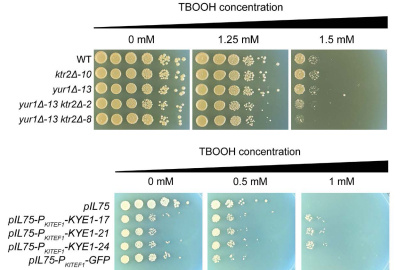
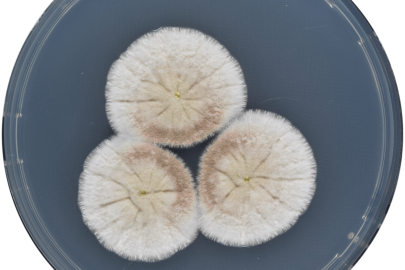

The Biological and Environmental Research (BER) program supports scientific research and facilities to achieve a predictive understanding of complex biological, earth, and environmental systems with the aim of advancing the nation’s energy and infrastructure security. The program seeks to discover the underlying biology of plants and microbes as they respond to and modify their environments. This knowledge enables the reengineering of microbes and plants for energy and other applications. BER research also advances understanding of the dynamic processes needed to model the Earth system, including atmospheric, land masses, ocean, sea ice, and subsurface processes.
Over the last three decades, BER has transformed biological and Earth system science. We helped map the human genome and lay the foundation for modern biotechnology. We pioneered the initial research on atmospheric and ocean circulation that eventually led to climate and Earth system models. In the last decade, BER research has made considerable advances in biology underpinning the production of biofuels and bioproducts from renewable biomass, spearheaded progress in genome sequencing and genomic science, and strengthened the predictive capabilities of ecosystem and global scale models using the world’s fastest computers.
BER supports three DOE Office of Science user facilities, the Atmospheric Radiation Measurement (ARM) user facility, Environmental Molecular Sciences Laboratory (EMSL), and Joint Genome Institute (JGI). These facilities house unique world-class scientific instruments and capabilities that are available to the entire research community on a competitive, peer review basis. Additionally, four DOE Bioenergy Research Centers were established to pursue innovative early-stage research on bio-based products, clean energy, and next-generation bioenergy technologies.
BER Science Highlights
-
 A new study integrates fire processes into an Earth system model to help scientists simulate and better understand the impacts of pyrocumulonimbus clouds.March 12, 2026
A new study integrates fire processes into an Earth system model to help scientists simulate and better understand the impacts of pyrocumulonimbus clouds.March 12, 2026 -
 Scientists transformed an old drug into a potent COVID-19 treatment effective against drug-resistant variants.February 19, 2026
Scientists transformed an old drug into a potent COVID-19 treatment effective against drug-resistant variants.February 19, 2026 -
 Researchers identify butylamine as a promising solution to many challenges at biorefineries.February 5, 2026
Researchers identify butylamine as a promising solution to many challenges at biorefineries.February 5, 2026 -
 Researchers demonstrated an efficient strain of bacteria for bioproduction that grows on the promising feedstock formate.February 3, 2026
Researchers demonstrated an efficient strain of bacteria for bioproduction that grows on the promising feedstock formate.February 3, 2026 -
 Scientists uncover a hidden feature of protein translation in green algae, offering a new perspective on the basic rules of gene expression.December 1, 2025
Scientists uncover a hidden feature of protein translation in green algae, offering a new perspective on the basic rules of gene expression.December 1, 2025 -
Study provides a framework for connecting genetic mechanisms and trait variation across diverse yeast species.September 29, 2025
Study provides a framework for connecting genetic mechanisms and trait variation across diverse yeast species.September 29, 2025 -
Researchers investigate the connections between Aspergillus species, demonstrating their usefulness for producing biofuels and bioproducts.September 25, 2025
Researchers investigate the connections between Aspergillus species, demonstrating their usefulness for producing biofuels and bioproducts.September 25, 2025 -
 A new approach accelerates how quickly scientists can identify genes involved in environmental acclimation and understand bacterial stress.September 2, 2025
A new approach accelerates how quickly scientists can identify genes involved in environmental acclimation and understand bacterial stress.September 2, 2025 -
 A fast, automated, and high-throughput pipeline is improving the speed of plant engineeringAugust 26, 2025
A fast, automated, and high-throughput pipeline is improving the speed of plant engineeringAugust 26, 2025 -
 A novel laser-based method provides unprecedented detail on the nutrient cycle in root ecosystems.July 28, 2025
A novel laser-based method provides unprecedented detail on the nutrient cycle in root ecosystems.July 28, 2025
BER Program News
BER Subprograms
Biological Systems Science
Research to understand complex interactions that determine the function of biological systems, from single cells to plants.
Earth and Environmental System Sciences
Research on atmosphere, land, and water components and interactions that help inform regional and global earth system modeling.
DOE Bioenergy Research Centers
Supports fundamental research addressing the challenge of converting renewable plant biomass (non-food) to biofuels and bioproducts.
BER DOE Office of Science User Facilities
Atmospheric Radiation Measurement (ARM)
Observation network for understanding cloud and aerosol interactions with the Earth’s surface.
Environmental Molecular Sciences Laboratory (EMSL)
Houses more than 50 premier instruments and modeling resources that can be accessed to understand the physical, chemical, and cellular processes of biological and environmental systems.
Joint Genome Institute
Provides the research community with high throughput DNA sequencing, synthesis and analysis of plants, microorganisms and microbiomes in support of BER biological systems science research.
BER Research Resources
Contact Information
Biological and Environmental Research
U.S. Department of Energy
Germantown Building
1000 Independence Avenue., SW
Washington, DC 20585
P: (301) 903 - 3251
F: (301) 903 - 5051
E: sc.ber@science.doe.gov







